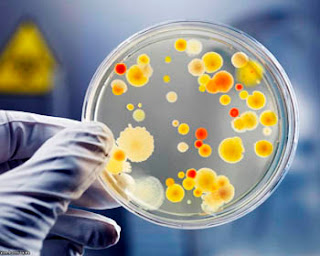

Дифтерия должна исчезнуть! |
Вред минеральной ваты.
Почему плачет ребенок?
Цементный завод - вред для человека.
Бессонница.

|
Метки: дифтерия |
Бессонница. |
Вред минеральной ваты.
Цементный завод - вред для человека.
Почему плачет ребенок?


|
Метки: бессонница |
Цементный завод - вред для человека. |
Почему плачет ребенок?
Вред минеральной ваты.

Загрязненная производством цемента вода попадает к нам в дом. Постоянное употребление такой воды приводит к постоянным раздражениям слизистых оболочек желудка и двенадцатиперстной кишки, что чревато гастритами и язвами.|
Метки: завод вред человек |
Вред минеральной ваты. |


|
Метки: вред вата |
Почему плачет ребенок? |


|
Метки: ребенок |
Как убрать угри и черные точки навсегда? |
Живительный сок алоэ
ЧИСТИМ КРОВЬ САМЫМИ БЕЗОПАСНЫМИ СПОСОБАМИ
Картофельный гратен
Проверенные поколениями народные средства для сосудов
Уникальный отвар для нормализации работы ЖКТ
ПРАВИЛА ПОХУДЕНИЯ, КОТОРЫЕ ДОЛЖНА ЗНАТЬ КАЖДАЯ ЖЕНЩИНА
Видео за несколько минут показывает 9 месяцев жизни в утробе матери
Котлеты морковно-сырные
Секрет гармонии тела и души!
Диетическая яблочная шарлотка для худеющих! На 100 грамм всего 78,68 ккал!


|
|
КАК УСПОКОИТЬ НЕРВЫ |
Видео за несколько минут показывает 9 месяцев жизни в утробе матери
Котлеты морковно-сырные
Секреты красоты одной строкой
Коктейль со свеклой и кефиром для похудения
Овощной суп. Легкий постный овощной суп
«Бестолковые» упражнения: семь типов
Укрепи кости и остеопороза не будет
Мысли и советы гениального, великого кардиохирурга, академика, профессора Амосова Николая Михайловича
Диетическая яблочная шарлотка для худеющих! На 100 грамм всего 78,68 ккал!
Морковно-творожный пудинг

|
|
Котлеты морковно-сырные |
ЧТО ЗНАЧАТ ЛИНИИ НА ЛАДОНИ?
3 преимущества употребления чеснока на голодный желудок
Лучшие рецепты народной медицины от болезни щитовидной железы
Интенсивная тренировка ног
Укрепи кости и остеопороза не будет
Свекольный салат с маринованными огурцами
Телосложение и болезни
Овощной суп. Легкий постный овощной суп
ЛЕЧЕНИЕ ОСТЕОХОНДРОЗА НАРОДНЫМИ МЕТОДАМИ
ЧИСТИМ КРОВЬ САМЫМИ БЕЗОПАСНЫМИ СПОСОБАМИ

|
|
Вечерняя йога: практика перед сном |
Эфирные масла, способы применения и результаты их действия (самый полный сборник)
Тяжелое, но очень эффективное упражнение «Бурпи»
ПРАВИЛА ПОХУДЕНИЯ, КОТОРЫЕ ДОЛЖНА ЗНАТЬ КАЖДАЯ ЖЕНЩИНА
Синдром отличника. Невроз у ребёнка нередко вызывают сами родители
Овощной пирог без теста
ЧТО ЗНАЧАТ ЛИНИИ НА ЛАДОНИ?
Интенсивная тренировка ног
НЕ ЕМ И НЕ ХУДЕЮ! ПОЧЕМУ НЕ РАБОТАЮТ ДИЕТЫ
Главное лечебное свойство софоры японской - очищение сосудов!
Если вы веган...











|
|
Укрепи кости и остеопороза не будет |
Секрет гармонии тела и души!
ЧИСТИМ КРОВЬ САМЫМИ БЕЗОПАСНЫМИ СПОСОБАМИ
Лучшие рецепты народной медицины от болезни щитовидной железы
Мысли и советы гениального, великого кардиохирурга, академика, профессора Амосова Николая Михайловича
Вот полный список проблем, которые решает активированный уголь
Старинные рецепты для продления молодости
Секреты красоты одной строкой
Хотите жить долго и не болеть - узнайте о точке долголетия
3 преимущества употребления чеснока на голодный желудок
Тяжелое, но очень эффективное упражнение «Бурпи»

|
|